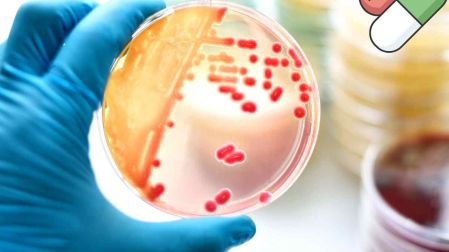
thumb

La FDA aprueba dos nuevos medicamentos para tratar la gonorrea
Ambas medicinas atacan la estructura de la bacteria e impiden que se replique en el organismo. Además ofrecen una tasa de curación superior al 90%

La Administración de Alimentos y Medicamentos (FDA) aprobó dos nuevos fármacos orales para combatir la gonorrea, lo que permitirá que quienes padecen esta afección cuenten con vías terapéuticas alternativas.
La disponibilidad de estas opciones facilita el acceso a curas rápidas que erradican el problema de raíz, tanto en adultos como en jóvenes. Este avance ocurre en un momento en que la medicina requiere fármacos novedosos ante la pérdida de eficacia de los antibióticos previos.
¿Cuáles son los medicamentos contra la gonorrea que aprobó la FDA?
La FDA autorizó dos sustancias que ofrecen rutas de ataque distintas para eliminar la bacteria Neisseria gonorrhoeae. Ambos fármacos logran tasas de curación superiores al 90% en condiciones de estudio clínico controlado:
- Nuzolvence (Zoliflodacina): Se presenta en gránulos que se disuelven en agua para una sola toma oral. Está diseñada para evitar el uso de agujas.
- Blujepa (Gepotidacina): Compuesto por tabletas orales, este medicamento actúa inhibiendo la replicación bacteriana, lo que dificulta que el patógeno genere defensas inmediatas.
- Mecanismo de acción: Atacan directamente la estructura de la bacteria en casos de gonorrea no complicada. Su diseño químico permite evadir las resistencias que el organismo ya desarrolló contra terapias antiguas.

¿Quiénes podrán usar los medicamentos para la gonorrea?
La administración de estos fármacos está sujeta a criterios específicos de edad y masa corporal para garantizar tu seguridad. La FDA establece los siguientes lineamientos para su uso en la población:
Nuzolvence está autorizado para adultos y adolescentes mayores de 12 años con un peso mínimo de 35 kilos. Esta apertura es fundamental para que atiendas a un sector joven que registra altas tasas de infección.
Blujepa se indica también para mayores de 12 años, pero requiere que tengas un peso corporal de al menos 45 kilos. Se posiciona como la alternativa principal si presentas alergias o cuando el tratamiento estándar no es viable para ti.
La llegada de estos fármacos es importante porque la bacteria ha desarrollado inmunidad a ciertos medicamentos. Diversificar los tratamientos orales reduce la presión evolutiva y protege tu salud reproductiva a largo plazo.

¿Cuáles son los síntomas de la gonorrea?
El diagnóstico temprano previene daños irreversibles en tu sistema reproductor. La infección puede presentarse de forma asintomática o manifestar señales claras que requieren tu atención médica inmediata, de acuerdo con los Centros para el Control y la Prevención de Enfermedades (CDC) y la Organización Mundial de la Salud (OMS):
Síntomas en mujeres:
- Dolor o ardor leve al momento de orinar.
- Flujo vaginal inusual que puede confundirse con infecciones comunes.
- Sangrado vaginal entre periodos menstruales.
Síntomas en hombres:
- Sensación de ardor intenso al orinar.
- Secreciones blancas, amarillas o verdes a través del pene
- Dolor o inflamación en la zona de los testículos.
Afectaciones en otras zonas del cuerpo:
- Garganta: Dolor persistente tras haber tenido contacto oral.
- Recto: Secreciones, picazón, sangrado o dolor al evacuar tras contacto anal.

Ignorar estas señales puede causar inflamación pélvica o infertilidad por cicatrización de conductos. La detección mediante pruebas de laboratorio regulares es la estrategia más efectiva para mantener la salud integral.
Con la llegada de Nuzolvence y Blujepa, la ciencia médica ofrece soluciones contra las bacterias resistentes. El uso de métodos de barrera y la revisión periódica con especialistas siguen siendo las mejores prácticas preventivas.
